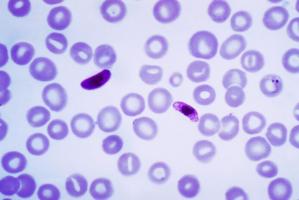
Le paludisme cérébral frappe plus de 575.000 personnes chaque année, et, de manière disproportionnée les jeunes enfants vivant en Afrique subsaharienne

Vous recherchez une actualité ou un dossier
Recherche (liste)
Mode d'affichage :
-
PALUDISME : Une IST pour dégommer les moustiques ?
Actualité publiée le 12/07/2025Moustiques et santé : les stratégies de prévention à connaître
Actualité publiée le 03/04/2025
-
PALUDISME : Pourquoi le vaccin est moins efficace chez le nourrisson
Actualité publiée le 03/11/2024PALUDISME : Un nouveau candidat efficace contre les résistances ?
Actualité publiée le 28/09/2024
-
PALUDISME : Le développement sexuel du parasite enfin décrypté et cartographié
Actualité publiée le 05/05/2024PALUDISME : Mettre le parasite au régime ?
Actualité publiée le 18/03/2024
-
PALUDISME : Des anticancéreux efficaces contre Plasmodium
Actualité publiée le 17/07/2023PALUDISME : Désorienter le parasite pour l’empêcher de prospérer
Actualité publiée le 07/07/2023
-
PALUDISME : Il touche toujours 3 enfants sur 10 en Afrique subsaharienne
Actualité publiée le 24/06/2023PALUDISME : Pour mieux infecter, le parasite se synchronise avec l’horloge biologique
Actualité publiée le 13/06/2023
-
PALUDISME : Une infusion contre Plasmodium falciparum
Actualité publiée le 14/05/2023PALUDISME : La moustiquaire traitée avec au moins 2 pesticides s’impose
Actualité publiée le 29/01/2023
-
PALUDISME : Les vaccins à ARNm aussi
Actualité publiée le 04/12/2022PALUDISME : Les promesses antiparasitaires d’un anticancéreux
Actualité publiée le 03/12/2022
-
PALUDISME : 2 protéines cibles, essentielles à la survie du parasite
Actualité publiée le 09/04/2022ANTIBIORÉSISTANCE : Elle tue plus que le VIH-SIDA ou le paludisme
Actualité publiée le 23/01/2022
-
SCLÉROSE en PLAQUES : Une nouvelle indication pour l'hydroxychloroquine ?
Actualité publiée le 18/01/2022PALUDISME et GROSSESSE : L’azithromycine réduit aussi le risque de naissance prématurée
Actualité publiée le 14/10/2021
-
PALUDISME : Un anticorps monoclonal pour le prévenir ?
Actualité publiée le 15/08/2021PALUDISME : Un candidat vaccin efficace à 75%
Actualité publiée le 25/04/2021
-
PALUDISME : Preuves d’efficacité des anticorps monoclonaux
Actualité publiée le 11/03/2021PALUDISME : Un patch de détection à microaiguilles
Actualité publiée le 11/11/2020
-
COVID-19 : Cibler l’hôte humain plutôt que le pathogène ?
Actualité publiée le 12/08/2020PALUDISME : Comment le parasite synchronise son cycle avec celui de l’hôte
Actualité publiée le 19/05/2020
-
COVID-19 : La petite étude qui challenge l’hydroxychloroquine
Actualité publiée le 27/03/2020COVID-19 : L’espoir de l’hydroxychloroquine
Actualité publiée le 23/03/2020
-
PALUDISME : Découverte de la protéine responsable des fuites cérébrales
Actualité publiée le 11/02/2020PALUDISME : Et si les moustiques ne pouvaient plus nous sentir ?
Actualité publiée le 31/10/2019
-
PALUDISME : Ils brisent le cycle de vie du parasite
Actualité publiée le 30/10/2019CACHEXIE : Une infection virale peut la déclencher
Actualité publiée le 12/07/2019
-
L’ÉDITION du GÉNOME contre les maladies vectorielles
Actualité publiée le 11/02/2019PALUDISME: Changer notre saveur pour dégoûter le moustique
Actualité publiée le 13/10/2016
-
PALUDISME: Et si les moustiques préféraient les animaux aux hommes?
Actualité publiée le 26/09/2016